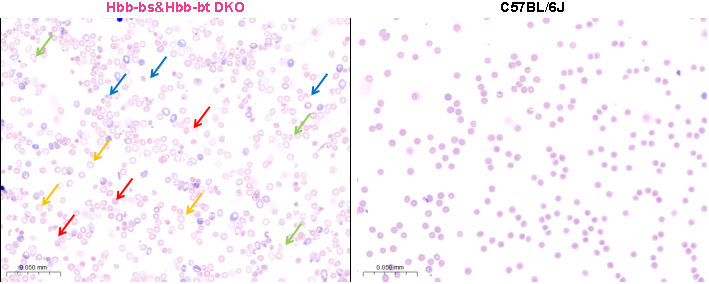
基因编辑疗法

2023年12月8日,FDA一次批准了两个针对镰状细胞病(SCD)的基因治疗,其中有首个基因编辑疗法——同时也是首个基于CRISPR基因编辑技术的疗法:CASGEVY[1]。作为全球首个获批的CRISPR/Cas9基因编辑疗法,CASGEVY代表了CRISPR技术临床转化“从0到1”的突破,同时开启了基因编辑赛道的新纪元。
血液遗传性疾病研究
这一新闻给了从事基因编辑疗法研究的公司更多信心。在国内,研究人员也瞄准利用CRISPR技术开发药物,从而治疗包括地中海贫血、镰状细胞病在内的血液遗传性疾病。以输血依赖型B-地中海贫血为例,国内中重度患者人数达30万人,因此,中国的基因编辑疗法产业早日取得新突破也成为了许多人的期待。
为助力血液疾病研究,赛业生物针对血友病、β地中海贫血等开发了一系列基因编辑模型,包含基因敲除、基因敲入、点突变等类型,同时,我们也可根据研究人员的需求进行定制或合作开发。

模型验证数据
——以β地中海贫血
Hbb-bs&Hbb-bt DKO小鼠为例
Hbb-bs&Hbb-bt DKO小鼠是同时敲除了小鼠Hbb-bs和Hbb-bt基因所构建的β地中海贫血疾病模型。该模型纯合致死,杂合小鼠呈现血红蛋白含量、红细胞计数、红细胞压积、平均红细胞血红蛋白浓度、红细胞分布宽度、血小板数、脾脏大小和红细胞形态等指标异常的严重地中海贫血典型特征并具有生育能力。因此该小鼠可用于与β地中海贫血相关的研究。
(1)生长曲线

杂合Hbb-bs&Hbb-bt DKO小鼠和野生型(WT)小鼠的体重变化曲线
雌性和雄性杂合Hbb-bs&Hbb-bt DKO小鼠均呈现和野生型小鼠较为一致的生长状况。
(2)生存曲线

杂合Hbb-bs&Hbb-bt DKO小鼠和野生型(WT)小鼠的生存曲线
雄性杂合Hbb-bs&Hbb-bt DKO小鼠在第13周开始出现死亡情况,雌性杂合Hbb-bs&Hbb-bt DKO小鼠在第15周开始出现死亡情况。
(3)血常规检测

14周龄雄性杂合Hbb-bs&Hbb-bt DKO小鼠和野生型(WT)小鼠血常规检测
血常规检测结果表明,与野生型小鼠相比,杂合Hbb-bs&Hbb-bt DKO小鼠的红细胞计数(RBC)、血红蛋白含量(HGB)和红细胞压积(HCT)显著下降,平均红细胞血红蛋白浓度(MCHC)略有下降,而红细胞分布宽度(RDW)和血小板计数(PLT)明显上升。这些参数变化与相似基因突变类型导致的β地中海贫血临床表型相似。
(4)血涂片分析
14周龄雄性杂合Hbb-bs&Hbb-bt DKO小鼠和C57BL/J野生型小鼠血涂片检测分析
血涂片分析结果显示杂合Hbb-bs&Hbb-bt DKO小鼠有核细胞数占比增加,红细胞中央浅染区扩大且出现较多异形、碎片红细胞和有核红细胞。其外周血中存在靶形红细胞(黄色箭头)、棘形状红细胞(红色箭头)、泪滴状红细胞(绿色箭头)和破碎状红细胞(蓝色箭头)等多种异常形态红细胞。C57BL/J野生型小鼠红细胞形态结构完整,呈现双凹圆盘状且未见明显异常。



